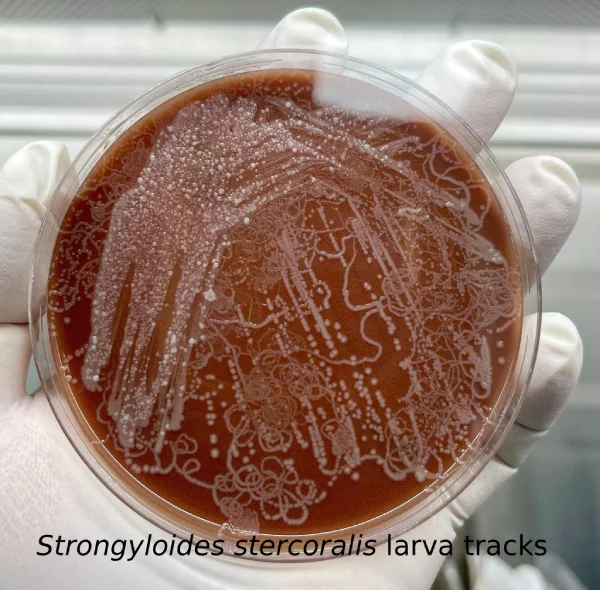

Table of Contents
Strongyloides stercoralis, commonly known as the threadworm, is a soil-transmitted intestinal nematode capable of causing chronic and potentially life-threatening infections. While less prevalent than other intestinal nematodes, it remains a significant global health concern, particularly in tropical and subtropical regions of Asia, Latin America, and Africa. Estimates suggest that 30–100 million people worldwide are affected, with sporadic cases in the United States and Europe due to travel or immigration from endemic areas.
The clinical presentation of strongyloidiasis ranges from asymptomatic carriage to severe disseminated disease, particularly in immunocompromised individuals, organ transplant recipients, and patients undergoing long-term corticosteroid therapy. Acute infections can cause pruritic rashes, epigastric pain, diarrhea, and pulmonary symptoms, whereas hyperinfection syndrome a rapid increase in worm burden may lead to sepsis, meningitis, or multi-organ involvement, often with fatal outcomes.
The diagnostic evaluation of Strongyloides stercoralis is critical for early detection, particularly in high-risk populations. Timely diagnosis informs the initiation of anthelmintic therapy, reduces the risk of hyperinfection, and guides preventive measures in immunocompromised patients. Traditional stool microscopy remains the first-line diagnostic method; however, its sensitivity is limited due to intermittent larval shedding. Consequently, advanced techniques including agar plate culture, serologic testing, and molecular assays (PCR) have been developed to enhance diagnostic accuracy.
From a public health perspective, detection of S. stercoralis aids in reducing transmission in endemic areas by guiding hygiene, sanitation, and screening initiatives, including pre-transplant assessments and surveillance in institutionalized populations. Clinicians, laboratory technicians, and public health authorities rely on robust diagnostic protocols to differentiate S. stercoralis from other nematodes, such as hookworms, which require different therapeutic approaches.
Principle of Strongyloides stercoralis Diagnosis
The diagnostic principle of S. stercoralis relies on the detection of its larvae in human specimens. The organism exhibits a complex life cycle comprising direct, indirect (free-living), and autoinfective cycles, which underlies its persistent infectivity and potential for hyperinfection.
Life Cycle and Pathophysiology
- Filariform larvae (infective) penetrate human skin from contaminated soil, entering the circulatory system and migrating to the lungs. From there, they ascend the bronchial tree, are swallowed, and establish themselves in the small intestine (duodenum and jejunum), where they mature into parthenogenetic females.
- Rhabditiform larvae (noninfective) are excreted in stool and can develop into free-living adults in the soil, producing additional filariform larvae capable of infecting humans.
- Autoinfection occurs when rhabditiform larvae in the intestine transform into filariform larvae that penetrate the intestinal mucosa or perianal skin, leading to chronic infection lasting decades (Rodríguez-Pérez et al., 2020).

Morphology
- Rhabditiform larvae: 250–380 μm long, short buccal capsule, large esophageal bulb, genital primordium visible mid-body.
- Filariform larvae: up to 500–630 μm long, slender, pointed tail, capable of surviving in soil for several days.
- Eggs: rarely seen in stool, 50–58 μm × 30–34 μm, thin-shelled (Grove, 2016).
Understanding larval morphology is essential for differentiating S. stercoralis from hookworm larvae, as misidentification may lead to inappropriate therapy.

The principle of diagnosis therefore is focused detecting larvae via microscopic examination, culture, or molecular assays, exploiting their presence in stool, or duodenal contents, and confirming identification through characteristic morphology.
Morphological Differentiation:
- Strongyloides rhabditiform larvae: short buccal capsule, prominent genital primordium.
- Hookworm larvae: longer buccal capsule, similar esophageal morphology.

Laboratory Procedure
Effective laboratory diagnosis of S. stercoralis requires careful specimen collection and processing to maximize sensitivity.
1. Specimen Collection
- Primary specimen: Fresh stool samples; multiple specimens over 3–7 days are recommended to improve sensitivity (approaching 100%) due to intermittent larval shedding (CDC, 2023).
- Secondary specimens: Duodenal aspirates, sputum, gastric washings in hyperinfection cases.
Tip: Avoid delays in examination, as rhabditiform larvae may transform into filariform larvae or die, reducing detection rates.
2. Concentration Techniques
- Direct wet mount: Useful for initial screening; larvae are observed under 10× or 40× objectives.(Saline or Iodine preparation)
- Formalin-ethyl acetate sedimentation: Increases larval concentration, reducing background debris.
- Agar plate culture (most sensitive):
- Place stool on nutrient agar, seal to prevent contamination.
- Incubate 48 hours at room temperature.
- Larvae leave bacterial tracks; wash agar surface with 10% formalin for sediment examination.
3. Optional Diagnostic Methods
- Entero-Test (string test): Capsule captures duodenal contents for larval detection.
- Larval culture (Harada-Mori technique): Filter paper strip method for developing filariform larvae.
- Serology: IgG ELISA detects anti-Strongyloides antibodies; useful in low-burden infections or when stool examination is inconclusive. Sensitivity >95% (CDC, 2023).
- Molecular detection (PCR): Detects S. stercoralis DNA with near 100% sensitivity and specificity; high-throughput multiplex panels are available.
4. Interpretation of Laboratory Findings
| Result | Interpretation | Clinical Note |
| Positive rhabditiform larvae | Active intestinal infection | Initiate ivermectin; repeat stool exams |
| Positive filariform larvae | Autoinfection/hyperinfection | Assess immunosuppression; monitor organs |
| Negative multiple specimens | Likely no infection | Consider serology or PCR if suspicion remains |
| Serology positive | Past or current infection | Confirm with parasitologic evidence before treatment |
| PCR positive | Active infection | High sensitivity; useful in low-burden cases |
Clinical Tip: Immunocompromised patients may present with larvae in multiple body fluids, necessitating broad specimen collection.
Clinical Significance
Early and accurate diagnosis of S. stercoralis has profound implications for patient care:
- Treatment : Ivermectin or alternative anthelmintics.
- Hyperinfection prevention: Particularly in transplant recipients, corticosteroid users, and HIV/AIDS patients.
- Public health: Guides interventions in endemic areas, including hygiene promotion and screening programs.
Interpretation of Results
- Positive Stool / Culture: Confirms active infection; initiate treatment.
- Negative Stool but Positive Serology: Suggests low-burden or chronic infection; repeat testing or PCR recommended.
- Hyperinfection / Disseminated Disease: Larvae detected in sputum, BAL fluid, or tissues; indicates severe infection requiring combined anthelmintic and antibiotic therapy.
Limitations
- Intermittent larval shedding reduces sensitivity of single stool microscopy (21%).
- Agar culture and PCR improve detection but are labor-intensive or costly.
- Serology may cross-react with other helminth infections; cannot distinguish past vs. current infection.
- Delayed specimen handling can lead to false negatives.
Precautions
- Follow BSL-2 laboratory protocols.
- Minimize aerosol exposure during stool handling.
- Immunocompromised patients should avoid contaminated soil or water.
Conclusion
Strongyloides stercoralis diagnosis is critical for patient care and prevention of hyperinfection. The parasite’s lifecycle, including autoinfection, necessitates sensitive detection methods. Stool microscopy, concentration techniques, agar plate culture, serology, and PCR are complementary, with morphological identification of larvae guiding therapy.
Early detection informs treatment, reduces severe complications, and enables preventive measures for high-risk populations. Laboratory safety and proper specimen handling protect staff, while public health interventions reduce transmission in endemic regions. Accurate and timely diagnosis remains pivotal in clinical management and improving patient outcomes.
Strongyloides stercoralis FAQs
References
- CDC. (2020). Strongyloidiasis. https://www.cdc.gov/parasites/strongyloides/
- García, L., & Rodriguez, M. (2019). Medical Parasitology. Elsevier.
- Haque, R., et al. (2017). Epidemiology and clinical features of Strongyloides stercoralis infection. Clinical Microbiology Reviews, 30(2), 567–584. https://doi.org/10.1128/CMR.00027-16
- Nutman, T. B. (2018). Human infection with Strongyloides stercoralis. Annual Review of Medicine, 69, 1–12.
- Rodríguez-Pérez, E. G., Arce-Mendoza, A., Saldívar-Palacios, R., Escandón-Vargas, K. (2020). Strongyloides stercoralis: Morphology and clinical implications. Biomédica, 40(Suppl 1), 32–36. https://doi.org/10.7705/biomedica.5071